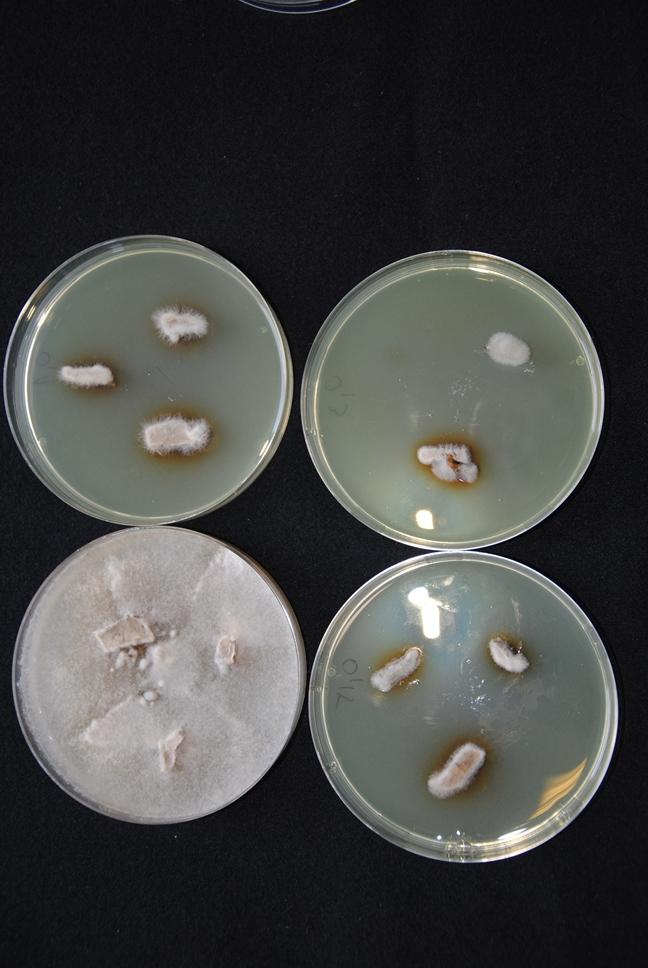

Dezynfekcja podstawą udanej produkcji
Będące w użyciu substancje mają działanie kontaktowe, dlatego żeby były skuteczne, muszą być dokładnie i równomiernie rozprowadzone na powierzchniach czy odkażanych narzędziach. Przed rozpoczęciem dezynfekcji należy sprzątnąć i usunąć wszystkie resztki roślinne, a także wynieść ze szklarni niepotrzebne sprzęty. Pamiętać należy, że dezynfekcja nie zwalcza szkodników występujących na uprawach. Co prawda mycie szklarni i odkażanie może ograniczać ich liczebność, ale część z nich przetrwa. Dlatego należy je zwalczyć po zakończeniu produkcji i zbiorze owoców za pomocą odpowiednich zoocydów. Warto również przeanalizować gdzie i w jakim nasileniu pojawiły się choroby, i te miejsca uprzątnąć oraz zdezynfekować szczególnie starannie. Następnie szklarnie łącznie z posadzkami należy dokładnie umyć i wówczas można przystąpić do właściwej dezynfekcji, wybierając odpowiedni środek biobójczy.
Badania nad takimi środkami wielokrotnie przeprowadzano w Klinice Chorób Roślin w Instytucie Ochrony Roślin-PIB w Poznaniu. Większość z nich została zarejestrowana jako preparaty do odkażania, ograniczające rozwój wirusa mozaiki pepino (Pepino mosaic virus, PepMV), bakterii powodującej bakteryjnego raka pomidora (Clavibacter michiganensis ssp. michiganensis, Cmm) oraz grzyba wywołującego szarą pleśń (Botrytis cinerea). Są to patogeny, które od lat przyczyniają się do powstawania strat zarówno w ilości, jak i jakości plonów.
Choroby wirusowe w uprawach pod osłonami
W trakcie badań prowadzonych w Klinice na roślinach pomidorów rosnących w szklarniach i tunelach wielokrotnie stwierdzamy występowanie objawów wskazujących na infekcję wirusem mozaiki pepino. Blaszki liściowe porażonych roślin są nieregularne, pofałdowane i skręcają się, a szczyty roślin często bywają zahamowane we wzroście. Innym rodzajem objawów, zależnym od szczepu PepMV, są żółtaczki obejmujące zwykle całą roślinę. Największy straty wirus powoduje wówczas, gdy objawy infekcji pojawiają się na owocach. W przypadku PepMV są to nierównomierne wybarwienia dojrzewających owoców, tzw. marmurkowatość.
Pojawił się również nowy wirus w uprawach pomidorów –Tomato brown rugose fruit virus (ToBRFV). Jest to wirus z rodzaju Tobamovirus, blisko spokrewniony z wirusem mozaiki tytoniu i wirusem mozaiki pomidora. Wirusy te są bardzo trwałe, trudne do usunięcia ze środowiska, w którym wystąpiły, a co najważniejsze – bardzo łatwo przenoszą się w sposób mechaniczny podczas zabiegów pielęgnacyjnych, a także z nasionami. Z tego samego rodzaju jest również wirus zielonej mozaiki ogórka (Cucumber green mottle mosaic virus, CGMMV), porażający ogórki. Wirus ten wystąpił w polskich szklarniach trzy lata temu, powodując bardzo duże straty w plonach. Na porażonych roślinach widoczne są bardzo silne mozaiki i pofałdowanie blaszki liściowej. Podobne objawy występują na owocach, przy czym wirus częściej występuje na ogórkach krótkich.
Zagrożenia bakteryjne
Nierzadkim zjawiskiem jest również występowanie na pomidorach uprawianych pod osłonami bakterii powodujących bakteryjnego raka pomidora (Clavibacter michiganensis ssp. michiganensis, CMM). Na porażonych roślinach obserwuje się więdnięcie liści spowodowane zaczopowaniem wiązek przewodzących przez namnażające się bakterie. Więdnące liście brunatnieją i zamierają, a w przypadku gwałtownie rozwijającej się infekcji można zaobserwować szybkie więdnięcie całego pędu rośliny oraz roślin rosnących w sąsiedztwie, co jest powodowane błyskawicznym przemieszczaniem się patogenu wraz z wodą. Należy jednak pamiętać, że objawy tego typu mogą być powodowane przez inne bakterie czy fitopatogeniczne grzyby.
Ze względu na trudności w bezpośrednim zwalczaniu zarówno chorób wirusowych, jak i bakteryjnych, kluczową rolę w ich ograniczaniu odgrywa szeroko pojęta profilaktyka, której jednym z elementów jest dezynfekcja powierzchni potencjalnie skontaminowanych przez szkodliwe mikroorganizmy.
Na rynku dostępnych jest wiele środków do odkażania, a część z nich była badana pod kątem skuteczności w Klinice Chorób Roślin.
Pierwszym etapem badań było sprawdzanie działania bezpośredniego preparatu w trzech różnych koncentracjach, dobieranych indywidualnie dla poszczególnych preparatów. Dla bakterii przygotowano murawę bakteryjną, na którą nanoszono krążki bibuły o średnicy 5 mm, a na nie po 10 µl badanego preparatu o danym stężeniu. Płytki inkubowano przez 24 godziny, a następnie mierzono strefy zahamowanego wzrostu. W przypadku grzybów przygotowywano pożywkę PDA, do której dodawano odpowiednią ilość środka, a po jej zastygnięciu nanoszono na nią kawałki pożywki z grzybnią B. cinerea. Obserwacje wzrostu grzybni obserwowano po około dwóch dobach. Na tym etapie badań stwierdzono hamujące wzrost bakterii i grzybów działanie środka, we wszystkich testowanych stężeniach. Ze względu na fakt, że kontakt środka do odkażania z wirusem będącym w komórkach roślinnych jest ograniczony, konieczne jest użycie wyższych stężeń dla dezynfekcji PepMV.
Kolejnym etapem badań było sprawdzenie przydatności testowanych środków, do dezynfekcji różnych powierzchni, takich jak: beton, folia, szkło i metal. Na małe fragmenty sterylnych materiałów nanoszono zawiesiny bakteryjne bądź strzępki grzyba i pozostawiano do wyschnięcia w temperaturze pokojowej. Następnie poddawano je działaniu środków dezynfekujących, pozostawiano na około dwie godziny do wyschnięcia i wykładano na płytki z odpowiednią pożywką, a następnie inkubowano przez 72 h. Po tym czasie obserwowano wzrost grzybni czy bakterii. Uzyskane przy pomocy metody odciskowej wyniki pozwalają stwierdzić, że efektywność środków dezynfekujących w znacznym stopniu zależy od rodzaju dezynfekowanej powierzchni. Te bardziej chropowate, takiej jak beton, mogą wymagać zastosowania nieznacznie większej koncentracji środka dezynfekcyjnego.
Skuteczność dezynfekcji uzależniona jest od wielu czynników, tj: czystość dezynfekowanej powierzchni i jej struktura, czas zwilżenia i ilość cieczy, stężenie preparatu i temperatura otoczenia. Obecność zanieczyszczeń, zwykle pochodzenia organicznego, znacznie obniża działanie środków, które mają z jednej strony utrudniony dostęp do odkażanej powierzchni, a z drugiej, są wiązane przez cząstki organiczne.
ALDEKOL PRO HORTI czy Menno Florades są środkami stosowanym do kompleksowego odkażania szklarni, w tym konstrukcji szklarni, betonowych podłóg, stołów, systemów nawadniania, pojemników uprawowych na rośliny, skrzynek, narzędzi i obuwia. Mają bardzo szerokie spektrum działania na wirusy, wiroidy, bakterie i grzyby (także na formy przetrwalnikowe). Aluclean – środek do dezynfekcji i mycia konstrukcji aluminowych. Radal – środek do czyszczenia, dezynfekcji i mycia linii nawadniająco-nawozowych.
Wirusy, bakterie i grzyby zwalczają również środki takie jak: VIROCID czy CID 20, które są bezpieczne dla środowiska, ulegają biodegradacji i nie zostawiają pozostałości. Do odkażania szklarni, tuneli czy magazynów, ale także gleby i podłoża można stosować preparaty typu: V-AGRO, AGRO FF, OXY AGRO. Preparatem zwalczającym patogeny, ale także wpływającym stymulująco na wzrost roślin może być HUWA SAN TR 50. Ogranicza on występowanie bakterii, szarej pleśni oraz chorób wiązek przewodzących roślin.
Jedną z najlepszych metod dezynfekcji jest pianowanie, czyli pokrycie powierzchni pianą, która jest dobrze widoczna i pozwala na równomierne pokryci. Ze względu na to, że piana nie spływa tak szybko jak ciecz i dłużej utrzymuje się na powierzchniach gładkich i pionowych, kontakt substancji aktywnej ze zwalczanymi patogenami jest zdecydowanie dłuższy.
Przeprowadzając dezynfekcję, ze względów bezpieczeństwa należy unikać kontaktu preparatu z roślinami (dużo z nich może być toksyczne dla roślin i powodować zaburzenia w ich rozwoju), a ponadto nie powinno się dopuszczać do zasychania preparatów na odkażanych powierzchniach. Niezmiernie istotne jest również to, że stosowane preparaty mogą być toksyczne bądź drażniące dla pracownika wykonującego zabieg, dlatego niezbędne jest stosowanie odzieży ochronnej.
dr hab. Natasza Borodynko-Filas, prof. nadzw. IOR–PIB
Klinika Chorób Roślin i Bank Patogenów
Instytut Ochrony Roślin – PIB
Fot. N. Borodynko-Filas
artykuł pochodzi z czasopisma
[caption id="attachment_25096" align="alignnone" width="300"]
STO[/caption]